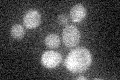
YGL142C
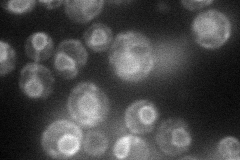
YGL142C
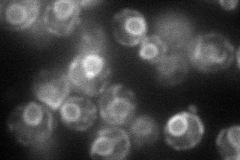
YGL142C
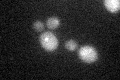
YGL142C

View description
Integral membrane protein involved in glycosylphosphatidylinositol (GPI) anchor synthesis; putative alpha 1,2 mannosyltransferase required for addition of the third mannose onto the GPI core structure; human PIG-Bp is a functional homolog
Localization:
Intensity:
Fold change:
Significance:
-
C’ GFP library in SD
below threshold15.89 -
N' NOP1pr-GFP in SD
ER63.2924 -
N' TEF2pr-mCherry in SD
ER88.3308 -
N' NATIVEpr-GFP in SD

below threshold14.7098 -
N' TEF2pr-VC and Cyto-VN in SD

ER31.454 -
C’ GFP library in SD+DTT
cytosol16.681.04No -
C’ GFP library in SD+H2O2

cytosol17.431.09No -
C’ GFP library in Starvation Media

cytosol13.940.87No -
C’ GFP library on the background of Pup2-DaMP

below threshold -
C’ GFP library on the background of CCT mutant

below threshold18.56651.1681No
